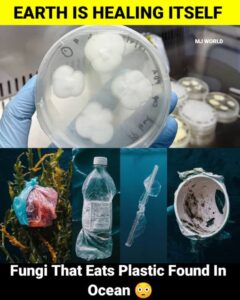
fungi

Health News

Congo Ebola Outbreak Tops 1,000 Cases as Violence and Displacement Fuel Crisis
The Ebola outbreak in eastern Democratic Republic of the Congo has passed 1,000 confirmed cases as health officials warn that violence, displacement and poor contact

Ebola-like Viruses: What India Needs to Know After Global Alerts on Orthoebolaviruses
Several species of Orthoebolavirus can cause severe outbreaks, the WHO warned, adding that health systems should increase surveillance, preparedness and community engagement to prevent spread.

Telangana HPV Vaccination Drive Reaches 91,289 as State Pushes to Close Coverage Gap
Telangana has breached the 91,000 beneficiaries mark in its HPV vaccination drive, but close to 2.85 lakh eligible girls are still to be vaccinated as

HPV Vaccine Brings Cervical Cancer Deaths for Young Women to Zero in England
A landmark study in England found that deaths from cervical cancer among vaccinated young women have plummeted to nearly zero, with no deaths recorded among

Cervical Cancer Prevention: Symptoms, Causes, Screening and Global Elimination Efforts
Cervical cancer is one of the most preventable cancers but still kills hundreds of thousands of women every year, particularly in low- and middle-income countries.

Ebola Disease: Symptoms, Spread, Treatment and Prevention Explained
Ebola disease is a serious and often fatal viral disease that spreads through direct contact with infected bodily fluids and contaminated surfaces. It remains a

Hantavirus Infection: Symptoms, Risks, Prevention and Medical Facts You Must Know
Deadly hantaviruses, carried by infected rodents, are a serious threat worldwide with high death tolls. Find out how to stay safe as concerns rise in

Samsung Galaxy Watch Can Predict Fainting Five Minutes Early, Study Says
Samsung says a clinical study has shown that the Galaxy Watch6 may be able to predict vasovagal syncope up to five minutes in advance, opening

Kedarnath : Yoga and Pranayama as Lifesavers for Devotees
The district administration at Kedarnath has launched free yoga and pranayama camps for pilgrims to address the extreme physical hardships faced during the trekking process

Surgery Miracle: Young Mother Gets a New Life with Bilateral Hand Transplant in Delhi
Surgery Miracle In a groundbreaking medical achievement at Delhi’s Sir Ganga Ram Hospital, a young woman who lost both her hands in a tragic accident

Algae Powered Air Purifies Device That Purifies Air and Boosts Oxygen Levels!
Algae Powered Air Purifier Device Harcourt Butler Technical University (HBTU) scientists have created a revolutionary biopurifier using algae. This compact device cleans polluted indoor air, removes toxic

Shocking Revelation: Pakistan Hospital Reuses Syringes, 331 Children Hit by HIV Outbreak
A secret investigation by the BBC shows that THQ Taunsa Hospital in Punjab is still doing unsafe things, even though the government has tried to

Therapeutic Plasma Exchange Saves Lives of Poison Ingestion Victims at KGMU
Therapeutic Plasma Exchange Lucknow’s King George’s Medical University pioneers TPE, rescuing 25 critical patients from toxic chemicals. Balrampur man Ramesh among latest survivors. Life-saving therapeutic plasma

DrugsControl News: CDSCO’s 860+ Raids on Fake GLP-1 Weight Loss Drugs, QR Codes Hammer Counterfeit Mafia
DrugsControl News DrugsControl reveals CDSCO’s nationwide blitz on unauthorized GLP-1s. Rajya Sabha discloses 860+ actions, codeine raids, DCGI’s 90 FDC bans – pharma earthquake! CDSCO’s

Drinking Tea Bags in Hot Water Invites Deadly Gut Diseases, Microplastics Trap
Microplastics Trap Meerut doctors warn: Billions of microplastics from tea bags cause gut inflammation and hormonal imbalance. Switch to loose tea leaves for safety. Microplastics

Black Garlic Benefits, Disadvantages, Home Recipe & Age-Based Consumption Guide
Black Garlic: Potent Health Benefits, Hidden Risks, Easy Home Recipe & Safe Age-Based Dosing Guide Fermented black garlic cloves offer potent antioxidants and unique health

Noida Launches 12-Day Measles-Rubella Vaccination Drive Across Schools
Gautam Budh Nagar health department launched a special measles-rubella (MR) vaccination campaign February 16, targeting students Classes 1-5 across government private schools Noida Greater Noida.

Silent Infections in Pregnancy: Hidden Dangers for Your Baby
Pregnancy brings heightened health vigilance, yet asymptomatic infections – silent infection threats undetected by symptoms – can severely impact fetal development without mothers noticing. Hepatitis

Nipah Virus India Outbreak Alarms China Chunyun Travel
Nipah Virus India A fresh Nipah virus cluster in West Bengal, India, with 5 confirmed cases—including a doctor and 3 nurses, one critical—has sparked widespread

Tagatose Low Calorie Sugar Cuts Insulin Spikes 100%
Tagatose Low Calorie Sugar Tufts University researchers have unveiled tagatose, a rare natural sugar that matches table sugar’s sweetness while slashing calories by 60% and

Weight Regain Strikes 4x Faster After Stopping GLP-1 Drugs Than Diet & Exercise
GLP-1 drugs like Ozempic and Wegovy deliver dramatic weight loss but trigger rapid regain upon cessation—four times faster than traditional diet and exercise programs. A

Woman Dies from Cervical Cancer Every 2 Minutes: WHO Urgent Call
This image is AI generated. Global, January 4, 2026 – Every two minutes, a woman loses her life to cervical cancer, the fourth leading cancer among

India Bans Nimesulide Tablets Over 100mg: Liver Risk Alert Issued
Bans Nimesulide Tablets/sbkinews.in The Indian government has imposed an immediate ban on the production, sale, and distribution of Nimesulide tablets exceeding 100mg dosage, citing severe

Winter Cold Sharply Raises Stroke Risk, Neurosurgeons Warn
As temperatures drop and foggy mornings return, doctors are warning that winter is also peak season for strokes, especially among people with existing heart or

Tramadol Under Fire: Popular ‘Safe’ Painkiller Linked To Minimal Relief, Serious Health Risks
A large evidence review has raised fresh concerns about tramadol, a popular prescription opioid often marketed as a “safer” alternative to stronger narcotic painkillers. The

Touch Activates Nervous System More Than Sound: Groundbreaking Study
A recent study published in the journal PLOS Mental Health has revealed that the human nervous system responds more strongly to tactile sensations than to sound

ICMR Discovers Genetic Switch Crucial for Pregnancy Initiation
Families longing for the joy of parenthood often face tremendous emotional and financial challenges when fertility issues arise. Despite advances in modern reproductive technologies like

Revolutionary ALS Gene Therapy Slows Neurodegeneration in 2025
Progressive and fatal neurodegenerative disease amyotrophic lateral sclerosis (ALS) is known to affect motor neurons. Gene therapies have provided a ray of hope for the

Biomarkers Discovered to Detect Early Signs of Diabetic Kidney Diseasese
A major step forward in preventive healthcare has been achieved through a new study that identifies unique blood biomarkers capable of detecting diabetic kidney disease

“Breakthrough Biomarkers Identified for Early Detection of Diabetic Kidney Disease by IIT Bombay”
Detection of Diabetes/sbkinews.in In a significant advancement for diabetes care, researchers from IIT Bombay, collaborating with Osmania Medical College, have discovered novel blood biomarkers capable

The Timeless Benefits of Sandalwood: Nature’s Gift for Wellness and Beauty
Benefits of Sandalwood/sbkinews.in Sandalwood, derived primarily from the heartwood of the Santalum album tree, has been revered for thousands of years across various cultures for

7 Amazing Aloe Vera Benefits Backed by Science for Health & Beauty
#Aloe Vera Benefits#Health Benefits of Aloe Vera#Aloe Vera for Digestion#Natural Remedies with Aloe Vera#Aloe Vera for Skin Aloe vera is a versatile medicinal plant with

10 Powerful Benefits of Fenugreek: The Ancient Herb Backed by Science
Benefits of fenugreek/sbkinews.in Fenugreek, a fragrant herb commonly used in cooking and traditional medicine, has long been celebrated for its remarkable health benefits. With increasing

Long-Term Sunlight Exposure Linked to Kidney Damage in Farmers
#Sunlight Exposure#Kidney Damage#Chronic Kidney Disease/sbkinews.in A new study published in The Lancet has drawn global attention to a growing health issue among India’s agricultural workforce. Researchers

“Comprehensive Health Benefits of Rosemary: Nature’s Powerhouse Herb for Mind, Body, and Skin”
Benefits of rosemary/sbkinews.in Rosemary is a Mediterranean aromatic herb that is prized for not just the variety of ways it can be used in the

“Top 8 Benefits of Amla (Indian Gooseberry) for Hair and Skin”
Benefits of Amla/sbkinews.in Amla, also known as Indian Gooseberry, has been a cornerstone of traditional Ayurvedic medicine for centuries. Revered for its potent medicinal properties,

10 Powerful Benefits of Coconut Oil and Coconut: Nature’s Versatile Superfood
Benefits of coconut oil/sbkinews.in Coconut oil and coconut have emerged as remarkable natural products, valued worldwide for their diverse health and beauty benefits. Extracted from

The Incredible Benefits of Green Tea: Nature’s Elixir for Modern Living
Benefits of green tea/sbkinews.in In a world pursuing wellness and balance, few natural beverages have earned as much global admiration as green tea. From ancient

“7 Powerful Health Benefits of Dragon Fruit You Should Know”
Dragon fruit health benefits/sbkinews.in Dragon fruit, also known as pitaya or pitahaya, is a vibrant, tropical fruit gaining popularity worldwide due to its striking appearance,

Gene Therapy Shows Promise for Diabetic Kidney Disease: A New Frontier in Treatment
#Gene Therapy for DKD/sbkinews.in Diabetic kidney disease (DKD) stands as the leading cause of end-stage renal failure globally, afflicting nearly one third of individuals living

Atrial cardiomyopathy significantly increases the risk of stroke and heart failure.
A new large-scale study from the UK Biobank has revealed alarming evidence linking atrial cardiomyopathy — a condition involving both electrical and structural abnormalities in

Unlocking the Power of Cardamom: 10 Science-Backed Health Benefits
Benefits of cardamom/sbkinews.in Cardamom, often called the “queen of spices,” has been used in traditional medicine for centuries due to its remarkable health properties. Recent

Unlocking the Power: 9 Real Health Benefits of Black Pepper Backed by Science
Black Pepper Health Benefits/sbkinews.in Black pepper, often called the “king of spices,” delivers an impressive array of scientifically-backed health benefits that make it a worthy

Emerging COVID-19 Variants: The “Razor-Blade” Throat Symptom May Be a Serious Red Flag
#COVID-19 variant #COVID-19 variant stratus update 2025 /sbkinews.in The global fight against COVID-19 continues to evolve as new variants emerge, posing fresh challenges to healthcare

Harvard-Trained Gastroenterologist Reveals 10 Best Foods for Digestive Health
10 Best Foods for Digestive Health/sbkinews.in Good digestion is fundamental to overall well-being, yet many people struggle with digestive discomfort and related health issues. In

Breast Cancer Detection Made Simpler: Shoolini University Develops Machine Learning Model for Early Diagnosis and Immediate Care
Breast cancer detection AI/sbkinews.in Solan, Himachal Pradesh: In a groundbreaking advancement, researchers at Shoolini University have developed an advanced machine learning model that promises to

Rising Erectile Dysfunction Among Men: The Role of Mental Health, Pornography And Lifestyle
Erectile Dysfunction/sbkinews.in Erectile Dysfunction (ED) has increasingly become a significant health concern, not only among older men but alarmingly among younger men as well. Recent

How Eating Cardamom Leaves Daily Boosts Heart Health, Blood Pressure, Immunity, and More
Cardamom leaves health benefits/sbkinews.in Cardamom, often dubbed the “queen of spices,” is not only treasured for its aromatic flavor in cooking and beverages but also

“PP405: The Promising New Treatment Poised to Change Hair Loss Therapy”
PP405 hair regrowth/sbkinews.in Hair loss is an age-old problem that has affected millions of people worldwide, causing emotional distress and reduced self-confidence. Despite the availability

8 Surprising Benefits of Ashwagandha Backed by Science
sbkinews.in Benefits of Ashwagandha In recent years, traditional Indian herbs have gained worldwide recognition for their remarkable health benefits, and Ashwagandha (Withania somnifera) stands at

“From Digestion to Immunity: 9 Surprising Benefits of Jaggery (Gur)”
SBKInews.in Benefits of Gur New Delhi, Aug 27 – Long before refined white sugar became a staple in kitchens, Indian households relied on jaggery – popularly

“Stop Eating After Sunset”: The Science and Success Behind Dr. Palaniappan Manickam’s Viral Early-Dinner Diet for Weight Loss
Diet for Weight Loss/sbkinews.in In a digital landscape saturated with complex diet plans and conflicting nutritional advice, a simple, ancient-inspired mantra is cutting through

The Magic of Garlic: 10 Health Benefits of 3 Cloves Daily
By Health & Lifestyle Desk | sbkinews.inDate: August 16, 2025 Garlic—commonly known as ‘Lahsun’ in India—has been used for centuries in traditional medicine, from Ayurveda

Study Suggests Eating Almonds Daily May Reduce Stress — Here’s How Much You Need
By Health Desk | sbkinews.inDate: August 17, 2025 Eating Almonds Daily Wondering whether a small handful of almonds could help ease stress? Recent research suggests

AIIMS Expert Warns: Soft Drinks May Cause Fatty Liver in Children—“Severe Cases Might Need a Transplant”
Side effects of soft drinks A growing health concern has caught the attention of medical experts: non-alcoholic fatty liver disease (NAFLD) is increasingly affecting children.

5 Heart-Healthy Foods to Add to Your Diet
Healthy food While there’s no single magic food for a healthy heart, a combination of nutrient-rich, natural foods can help protect your cardiovascular system. Here

Bird Flu Scare in UP’s Rampur: 15,000 Chickens Dead; 21-Day Ban on Poultry, Eggs Enforced Amid Rising Alarm
Rampur, Uttar Pradesh — August 13, 2025 A grave avian influenza (bird flu) outbreak has been confirmed in Rampur district, UP, triggering emergency containment measures:

Multiple Heavy Rain Spells in July Push Delhi’s Malaria Cases to 10-Year High
Delhi Malaria Cases New Delhi, August 10, 2025 — Delhi is grappling with a startling rise in malaria cases, reaching a 10-year high amid a

Healthy 29-Year-Old Dies of Sudden Cardiac Arrest While Working Out: Orthopaedic Surgeon Shares Chilling Details
Health CorrespondentPublished: August 7, 2025 Cardiac arrest In a tragic incident that has unsettled many fitness enthusiasts and medical professionals alike, a seemingly healthy 29-year-old

Indian Study Urges AQI Reform: Link Index to Real Health Risks
Environmental Health Policy AnalystPublished: August 4, 2025 The Study: From AQI to Health Risk Index A new policy paper by Indian researchers recommends transforming

Breakthrough Moment in Oncology: Russian Lab Sets Date for First Cancer Vaccine Treatments
Cancer vaccine treatment 1. What Russian Researchers Announced Russia is edging toward a major milestone in cancer therapy. The Gamaleya Research Institute, famous for

Lack of Sleep in Teenagers Linked to Significantly Higher Risk of High Blood Pressure
Health & Adolescent Wellness Analyst – based on over 5 years of desk‑based research Study Findings: Key Data from the American Heart Association Conference Lack

Unexpected Lung Cancer in Healthy Non‑Smokers: Genetic Mutation & Pollution Blamed
Medical & Health Editor – SBKI NewsPublished: August 1, 2025 When a 34‑year‑old Bengaluru IT professional and a 43‑year‑old teacher from Panipat were diagnosed with

Predict Your Heart Attack Risk with a Simple Coronary Artery Calcium Scan
SBKINEWS.IN | 30th July, 2025 Predict Cardiac Health Heart disease remains the biggest killer in India and the world. Now, more and more cardiologists and

World Hepatitis Day 2025: Factors That Might Put You At Risk
Public-Interest Reporter, SBKI News On World Hepatitis Day 2025, global health bodies and national authorities are once again sounding the alarm about a silent epidemic
🌍 Plastic-Eating Fungi Could Be a Glimmer of Hope in Cutting Ocean Pollution
SBK News | July 20, 2025 As the world grapples with the growing menace of plastic pollution in oceans, scientists have identified a surprising ally

Good Oral Health Can Reduce Cancer Risk, Improve Overall Wellness: AIIMS Delhi Study
July 20, 2025 | New Delhi A recent study conducted by AIIMS Delhi has revealed a critical link between oral hygiene and reduced cancer risk,

No Drip, No Delay: New Cancer Injection Revolutionizes Treatment Time and Patient Comfort
July 15, 2025 | New Delhi In a medical breakthrough set to transform the cancer treatment experience, health authorities in several countries—including the UK, US,
